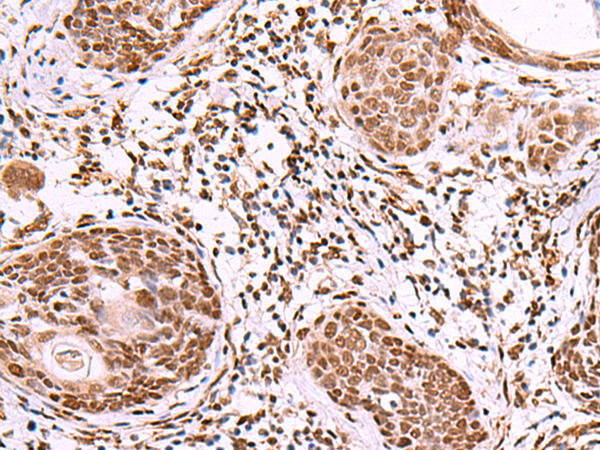

-
分类: 科研抗体货号: P13627别名: VL3A; CD49C; FRP-2; GAPB3; ILNEB; MSK18; VCA-2; VLA3a; GAP-B3应用: IHC反应种属: Human, Mouse
-
分类: 科研抗体货号: P13625别名: IA1; IA-1应用: IHC反应种属: Human, Mouse
-
分类: 科研抗体货号: P13645别名: IRXA2应用: WB,IHC反应种属: Human, Mouse
-
分类: 科研抗体货号: P13624别名:应用: IHC反应种属: Human, Mouse
-
分类: 科研抗体货号: P13644别名: IRX-5; IRXA1应用: WB,IHC反应种属: Human, Mouse
-
分类: 科研抗体货号: P13657别名: TIP27; ZNF802应用: IHC反应种属: Human, Mouse
-
分类: 科研抗体货号: P13643别名: IRX-1; IRXB1应用: WB,IHC反应种属: Human, Mouse
-
分类: 科研抗体货号: P13656别名: ANHD; IP3R2; CFAP48; INSP3R2应用: IHC反应种属: Human, Mouse, Rat
-
分类: 科研抗体货号: P13642别名: IFGGE; IRGC1; Iigp5; CINEMA; R30953_1应用: WB,IHC反应种属: Human, Mouse, Rat
-
分类: 科研抗体货号: P13655别名: H4P; IHRP; GP120; PK120; ITIHL1; PK-120; ITI-HC4应用: IHC反应种属: Human

鄂公网安备42018502007531号
鄂公网安备42018502007531号

